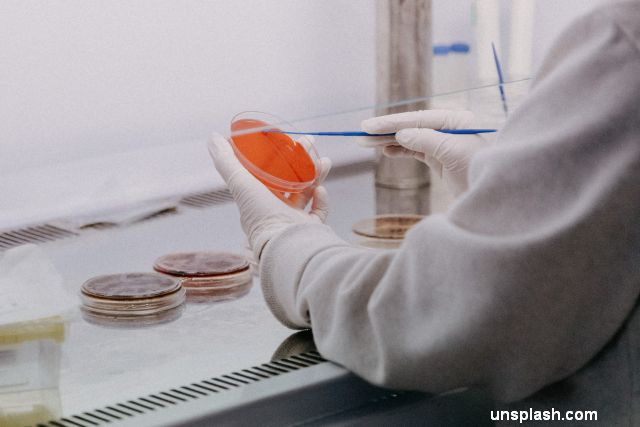

Bugetele pentru cercetare și dezvoltare în Uniunea Europeană
România alocă cei mai puțini bani pentru cercetare-dezvoltare în rândul statelor UE, cu un buget de 19 euro pe persoană.
Adaugă ca sursă preferată în Google
Lică Manolache, 03.08.2022, 15:46
Alocările bugetare pentru cercetare-dezvoltare în Uniunea Europeană s-au situat la 244 de euro pe persoană anul trecut, potrivit datelor publicate de Oficiul European pentru Statistică. Sumele au crescut cu o treime față de anul 2011, însă decalajele sunt mari între cele 27 de state membre.
Luxemburg, aproape 700 de euro pe persoană pentru cercetare
România este pe ultima poziție în Uniune cu alocări de numai 19 euro pe persoană, o creștere de plus de 8,5% comparativ cu 17,5 euro pe persoană în anul 2011. La coada clasamentului se mai află Bulgaria (24 de euro pe persoană), Letonia (45 de euro pe persoană) şi Ungaria (60 de euro pe persoană). De cealaltă parte, statele europene cu cele mai mari alocări bugetare pentru cercetare-dezvoltare sunt Luxemburg (689 de euro pe persoană), Danemarca (530 de euro pe persoană) şi Germania (471 de euro pe persoană).
În ultimii zece ani, cele mai mari creşteri procentuale pentru cercetare și dezvoltare au fost înregistrate în Letonia care a mărit alocările bugetare cu 212%, de la 14 euro pe persoană la 45 de euro pe persoană în 2021, urmată de Grecia (cu o creștere de 161%, de la 58 până la 152 de euro pe persoană) şi Ungaria care a dublat sumele (101%), de la 30 până la 60 de euro pe persoană. Sigura țară membră unde sumele pentru cercetare-dezvoltare au scăzut este Spania, unde cu alocarea a coborât cu 2%, de la 155 de euro pe persoană, până la 152 de euro pe persoană în anul trecut.
Alocările bugetare pentru cercetare-dezvolatre în 2021 / Sursa: Eurostat

Doar 11 milioane de euro în plus pentru cercetarea din România, în ultimii 10 ani
Alocările bugetare pentru cercetare-dezvoltare în Uniunea Europeană au crescut pânâ la 109,2 miliarde euro în 2021, echivalentul a 0,8% din PIB-ul UE. Suma reprezintă o creştere de 6% față de 2020 (102,7 miliarde euro) şi un avans de 35% în ultimul deceniu (81,1 miliarde euro în 2011). România a crescut, alocările pentru cercetare-dezvoltare cu doar 3,4% în zece ani, de la 352,82 milioane euro în 2011, până la 364,07 milioane de euro în 2021.
Eurostat a analizat datele și ca procent din PIB-ul fiecărui stat membru alocările bugetare pentru cercetare-dezvoltare, capitol la care trei state membre au înregistrat creșteri semnificative: Grecia (0,57 puncte procentuale), Germania (0,22 puncte procentuale) şi Luxemburg (0,13 puncte procentuale).
La polul opus, 14 state membre au înregistrat scăderi ale alocărilor bugetare ca procent din PIB au scăzut în perioada 2011-2021. România se află în plutonul țărilor cu cele mai mari scăderi, respectiv de 0.12%, de la 0,27% din PIB în 2011 până la 0,15% din PIB în 2021. În urma țării se situează Irlanda (minus 0,23 puncte procentuale) și Finlanda (minus 0,17 puncte procentuale). La nivelul UE, cercetarea și dezvoltarea a avut o creștere de 0,3% din PIB în ultimul deceniu, valoarea fiind de 0,75% din PIB în 2021.






























